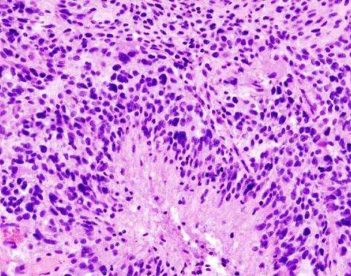

研究人员利用人工智能开创了一种治疗胶质母细胞瘤的潜在新免疫治疗方法
2024-08-02 10:48:33
•
来源:
导读 在一项关于胶质母细胞瘤的创新研究中,科学家利用人工智能(AI)对癌细胞进行重新编程,将其转化为树突状细胞(DC),树突状细胞可以识别癌细胞...
在一项关于胶质母细胞瘤的创新研究中,科学家利用人工智能(AI)对癌细胞进行重新编程,将其转化为树突状细胞(DC),树突状细胞可以识别癌细胞并指挥其他免疫细胞杀死它们。
胶质母细胞瘤是成人中最常见的脑癌,也是最致命的脑癌,不到 10% 的患者在确诊后五年内存活下来。尽管免疫疗法等新方法彻底改变了其他癌症的治疗方法,但它们对胶质母细胞瘤患者却收效甚微。部分原因是这些难以触及的脑肿瘤隐藏在血脑屏障后面,免疫细胞很难到达并消灭它们。
但由南加州大学凯克医学院领导的一项新研究利用人工智能来探索哪些基因控制着细胞的命运——例如,它是发展成心脏细胞、肺细胞还是癌细胞。
研究人员发现了可以重新编程胶质母细胞瘤细胞的基因,将它们转化为肿瘤内的免疫细胞,从而有效地瞄准其亲属癌细胞进行破坏。
在胶质母细胞瘤小鼠模型中,这种方法使存活几率提高了 75%。该研究结果发表在《癌症免疫学研究》上。
“这项开创性的研究利用人工智能的力量将胶质母细胞瘤细胞转化为免疫激活细胞,标志着癌症免疫治疗的重大进步,”该研究的主要作者、医学博士、哲学博士、神经外科和学副教授、凯克医学院神经肿瘤学部门主任 David Tran 表示。
免责声明:本文由用户上传,如有侵权请联系删除!

